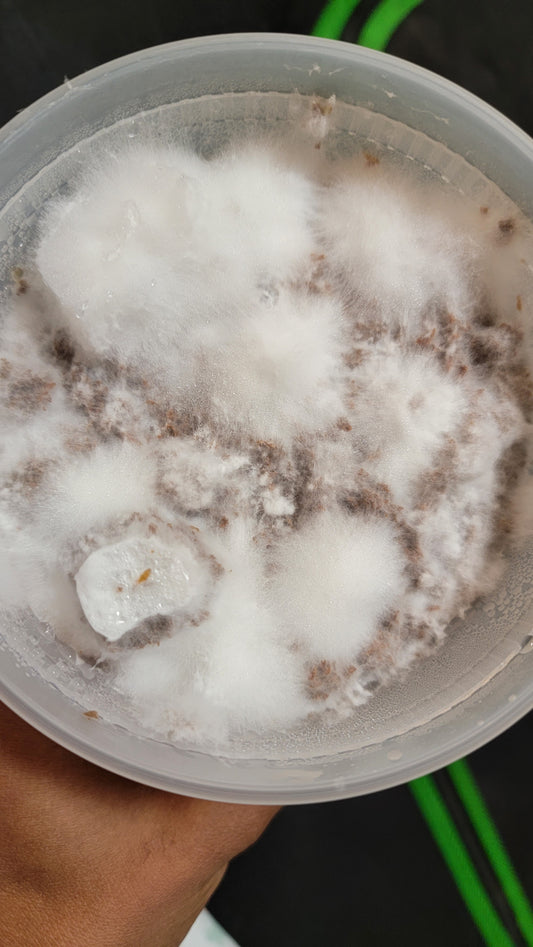

Read My Interview!
We were recently interviewed by North Spore on our approach to Mycology, what got us here, and where we're going! Very in-depth and worth a read!
Extractions, Teas, & Mycelium
A Drop of Mother Nature
-
Lion's Mane & Reishi Extract
Regular price $40.00 USDRegular priceUnit price / perSale price $40.00 USD -
Sold out32oz Kinshi Vessel (20 pack)
Regular price $160.00 USDRegular priceUnit price / perSale price $160.00 USDSold out -
Ultima (v2) Multi-Fungi Extraction
Regular price $50.00 USDRegular priceUnit price / perSale price $50.00 USD -
3-Piece Culture Booster Pack
Regular price $150.00 USDRegular priceUnit price / perSale price $150.00 USD -
Reishi & Lion's Mane Black Tea
Regular price $30.00 USDRegular priceUnit price / perSale price $30.00 USD -
Immune Booster Bundle
Regular price $100.00 USDRegular priceUnit price / perSale price $100.00 USD -
Lion's Mane Fruiting Kit
Regular price $40.00 USDRegular priceUnit price / perSale price $40.00 USD
Unique Genetics
Our Gene Library
The entirety of our available library were all foraged by Mycrodex. Coupled with our Breeding Program and Selection Process, we push to make unique varieties of Fungi available to others that would surprise even an avid enthusiast.
We update this list regularly and also have special, limited-time drops. Stay tuned!
Keeping it simple
Established in 2021
One of the biggest barriers of entry to Mycology are sterile conditions, but Mycrodex adopted and mastered the use of 'Oven-tek', which essentially uses an open electric oven as a flow-hood for inoculations. This opened the opportunity to practice cultivation for years with minimal investment. Within that time, we were able to grow and study more than 30 species of fungi!
Our entire journey has been documented on various social media platforms and is open for any to learn with us as we did.
1-on-1
Consulting/Private Lessons
Are you interested in learning to grow for yourself, family, or friends? We offer engaging, easy to understand lessons to get you confident in Fungi cultivation.
Versatility
Our Story
Mycrodex was created, initially on Instagram, to document our personal journey into learning Mycology.
Before long, it turned into an educational platform to help others do the same!
Our mission is to bring greater attention to the benefits and fun of Fungi! Cultivation is very accessible, even with limited resources, and we'd like to bring light to that in various ways.